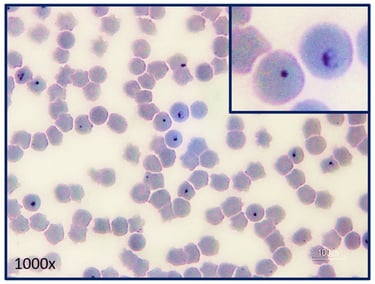

Cytauxzoon Felis ở Mèo: Nhận Diện, Điều Trị và Phòng Ngừa

Giới thiệu về Cytauxzoon Felis
Cytauxzoon felis là một loại ký sinh trùng thuộc nhóm Apicomplexa, chủ yếu lây nhiễm qua ve, và có thể gây ra bệnh nghiêm trọng ở mèo. Ký sinh trùng này chủ yếu tồn tại trong các khu vực có khí hậu nhiệt đới hoặc cận nhiệt đới, nơi mà mèo thường xuyên tiếp xúc với ve. Cytauxzoon felis tấn công hệ thống bạch cầu và làm tổn thương các tế bào máu, dẫn đến các vấn đề sức khỏe nghiêm trọng cho mèo.
Các triệu chứng khi mèo bị nhiễm Cytauxzoon felis có thể bao gồm sốt cao, suy nhược, và biểu hiện thiếu máu. Một số mèo cũng có thể gặp phải tình trạng vàng da, khó thở, hoặc thậm chí là co giật. Nếu không được điều trị kịp thời, bệnh có thể dẫn đến tử vong chỉ trong vòng vài ngày sau khi khởi phát triệu chứng. Do đó, nhận diện sớm là rất quan trọng.
Cytauxzoon felis lây lan chủ yếu thông qua các ve nhiễm ký sinh trùng. Khi ve cắn mèo để hút máu, chúng có thể truyền Cytauxzoon felis và gây ra bệnh. Mèo có nguy cơ cao hơn ở vùng có mật độ ve cao, và những mèo không được thăm khám y tế thường xuyên là đối tượng dễ bị lây nhiễm hơn. Sự gia tăng hoạt động ngoài trời của mèo cũng góp phần làm tăng nguy cơ nhiễm bệnh.
Do đó, việc hiểu biết về Cytauxzoon felis là rất cần thiết để bảo vệ sức khỏe cho mèo. Điều này không chỉ giúp các chủ nuôi nhận biết triệu chứng mà còn nâng cao ý thức về những biện pháp phòng ngừa cần thiết để bảo vệ thú cưng khỏi loại ký sinh trùng này.
Các triệu chứng của bệnh Cytauxzoon Felis
Bệnh Cytauxzoon felis là một căn bệnh do ký sinh trùng gây ra, chủ yếu ảnh hưởng đến mèo. Mèo nhiễm bệnh có thể thể hiện nhiều triệu chứng khác nhau, từ nhẹ đến nặng. Một trong những triệu chứng phổ biến nhất là sốt. Thân nhiệt của mèo có thể tăng lên đáng kể, thường dao động từ 39 đến 41 độ C. Nhiệt độ cơ thể cao dẫn đến cảm giác không thoải mái và có thể khiến mèo trở nên chán ăn.
Mệt mỏi cũng là triệu chứng thường gặp ở mèo mắc Cytauxzoon felis. Chúng có thể tỏ ra lờ đờ và ít hoạt bát hơn thường ngày, dành phần lớn thời gian để ngủ hoặc nghỉ ngơi. Điều này có thể làm cho chủ nuôi dễ dàng nhận biết sự khác thường trong hành vi của thú cưng. Nếu mèo không còn năng lượng như trước, đây có thể là dấu hiệu cho thấy chúng đang mắc bệnh.
Chán ăn là một triệu chứng khác mà người nuôi cần chú ý. Mèo có thể từ chối thức ăn mà chúng thường yêu thích hoặc ngừng ăn uống hoàn toàn. Trạng thái này có thể dẫn đến tình trạng giảm cân khá nhanh chóng. Ngoài ra, một số mèo có thể xuất hiện các triệu chứng khác như nôn mửa, tiêu chảy và dấu hiệu của mất nước.
Trong trường hợp không được điều trị kịp thời, các triệu chứng có thể chuyển biến nặng, dẫn đến tình trạng suy nội tạng hoặc thậm chí tử vong. Do đó, nếu nhận thấy các triệu chứng này ở mèo, chủ nuôi nên đưa thú cưng đi khám bác sĩ thú y ngay lập tức để được chẩn đoán và điều trị hợp lý.
Nguyên nhân gây bệnh Cytauxzoon Felis
Bệnh Cytauxzoon felis là một bệnh nhiễm trùng do ký sinh trùng gây ra, chủ yếu ảnh hưởng đến chó mèo. Ký sinh trùng này thường truyền từ mèo này sang mèo khác qua bọ ve, một loại côn trùng hành hạ. Bọ ve, đặc biệt là các loài như Amblyomma americanum, đóng vai trò quan trọng trong chu trình sống của Cytauxzoon felis. Khi bọ ve cắn mèo, nó có thể truyền ký sinh trùng vào cơ thể mèo qua dịch tiết từ tuyến nước bọt.
Khi Cytauxzoon felis xâm nhập vào cơ thể mèo, chúng bắt đầu phát triển trong tế bào hồng cầu và các tế bào miễn dịch. Điều này gây ra tình trạng nhiễm trùng nghiêm trọng, dẫn đến rối loạn các chức năng sinh lý của mèo. Ngoài ra, khi mèo bị nhiễm ký sinh trùng, hệ miễn dịch của nó cũng bị ảnh hưởng, khiến mèo dễ bị mắc các bệnh lý khác. Mèo trưởng thành, đặc biệt là những con có sức khỏe yếu, có nguy cơ cao hơn trong việc trải qua các triệu chứng nghiêm trọng.
Cytauxzoon felis thường xuất hiện nhiều hơn ở các vùng miền núi, nơi có nhiều bọ ve. Thời điểm dễ lây nhiễm thường rơi vào mùa hè và mùa thu. Việc mèo ra ngoài hoặc tiếp xúc với động vật có ve truyền bệnh sẽ có khả năng nhiễm bệnh cao hơn. Việc hiểu rõ chu trình sống của ký sinh trùng và sự lây lan qua vecto truyền bệnh là rất cần thiết để xác định các biện pháp phòng ngừa thích hợp, từ đó bảo vệ sức khỏe cho mèo yêu của bạn.
Phương pháp chẩn đoán Cytauxzoon Felis
Chẩn đoán Cytauxzoon felis thường đòi hỏi sự kết hợp giữa triệu chứng lâm sàng và các xét nghiệm chuyên biệt để xác định xem mèo có bị nhiễm ký sinh trùng này hay không. Một trong những dấu hiệu đầu tiên mà bác sĩ thú y sẽ chú ý là tình trạng sức khỏe tổng quát của mèo. Những triệu chứng như sốt cao, yếu đi, chán ăn, và vàng da có thể là dấu hiệu cho thấy mèo cần phải được kiểm tra thêm.
Để đưa ra chẩn đoán chính xác, veterinarians thường bắt đầu với việc lấy mẫu máu. Mẫu máu này sẽ được phân tích dưới kính hiển vi để tìm kiếm sự hiện diện của tế bào bạch cầu bị ký sinh trùng. Ngoài việc xét nghiệm máu, có thể yêu cầu thực hiện các phương pháp chẩn đoán khác như xét nghiệm PCR, một kỹ thuật xác định DNA của ký sinh trùng trong mẫu máu. Đây là một phương pháp chính xác và nhạy cảm, giúp phát hiện Cytauxzoon felis ngay cả trong giai đoạn đầu của sự nhiễm bệnh.
Trong một số trường hợp, bác sĩ thú y có thể yêu cầu kiểm tra nội soi hoặc siêu âm để đánh giá tình trạng các cơ quan bên trong của mèo. Việc sử dụng các công nghệ hình ảnh này hỗ trợ trong việc phát hiện sự tắc nghẽn hoặc tổn thương ở các cơ quan do ký sinh trùng gây ra. Tất cả các xét nghiệm và quy trình thăm khám này đều nhằm giúp bác sĩ thú y có cái nhìn rõ ràng và chính xác về tình trạng sức khỏe của mèo, từ đó đưa ra phác đồ điều trị thích hợp nhất.
Điều trị bệnh Cytauxzoon Felis
Bệnh Cytauxzoon felis, một bệnh ký sinh trùng nguy hiểm, ảnh hưởng nghiêm trọng đến sức khỏe của mèo. Để điều trị hiệu quả cho những chú mèo bị nhiễm bệnh, việc tiến hành điều trị kịp thời và phù hợp là rất quan trọng. Thông thường, điều trị bệnh này bao gồm việc sử dụng thuốc chống ký sinh trùng, trong đó có Atovaquone và Azithromycin, đã cho thấy kết quả tích cực trong việc tiêu diệt ký sinh trùng Cytauxzoon felis.
Bên cạnh việc sử dụng thuốc, các biện pháp hỗ trợ điều trị cũng rất cần thiết. Đối với những chú mèo mắc bệnh nặng, việc truyền dịch và cung cấp hỗ trợ dinh dưỡng có thể giúp cơ thể của chúng hồi phục tốt hơn. Ngoài ra, việc theo dõi tình trạng sức khỏe của vật nuôi trong suốt quá trình điều trị cũng đóng vai trò quan trọng trong việc phát hiện sớm các biến chứng có thể xảy ra.
Quá trình hồi phục thường kéo dài và đòi hỏi chủ nuôi phải có kiên nhẫn. Các triệu chứng như sốt, yếu đuối và mất nước có thể xuất hiện trong thời gian điều trị. Do đó, việc cung cấp một môi trường an toàn và yên tĩnh giúp mèo nghỉ ngơi sẽ rất có lợi. Chủ nuôi cũng nên tuân thủ theo đúng phác đồ điều trị mà bác sĩ thú y đã chỉ định để đảm bảo rằng hiệu quả điều trị được duy trì tối đa.
Tuy nhiên, việc điều trị bệnh Cytauxzoon felis cũng phải đối mặt với một số rủi ro nhất định. Một số mèo có thể phản ứng không tốt với thuốc, dẫn đến các tác dụng phụ nghiêm trọng. Do đó, điều quan trọng là người nuôi phải thường xuyên theo dõi tình trạng sức khỏe và báo cáo ngay cho bác sĩ thú y nếu có dấu hiệu bất thường nào. Thực hiện các biện pháp phòng ngừa hiệu quả, như bảo vệ mèo khỏi bọ chét và ve, cũng là một cách rất tốt để giảm thiểu nguy cơ nhiễm bệnh tiến triển.
Phòng ngừa Cytauxzoon Felis cho Mèo
Phòng ngừa bệnh Cytauxzoon felis, một bệnh do ký sinh trùng gây ra, cho mèo là rất quan trọng trong việc bảo vệ sức khỏe của chúng. Đầu tiên, việc kiểm tra sức khỏe định kỳ tại bác sĩ thú y là cần thiết để phát hiện sớm bất kỳ dấu hiệu nhiễm bệnh nào. Các bác sĩ thú y sẽ có khả năng kiểm tra và phát hiện ký sinh trùng trong cơ thể mèo, từ đó có thể áp dụng các biện pháp điều trị hoặc phòng ngừa kịp thời.
Kiểm soát ve và bọ ký sinh cũng đóng vai trò quan trọng trong việc ngăn ngừa Cytauxzoon felis. Ve là một trong những nguyên nhân chính làm lây lan bệnh này. Chủ nuôi cần thận trọng và sử dụng các sản phẩm phòng ngừa ve, bao gồm thuốc nhỏ, vòng đeo cổ hoặc thuốc uống. Việc làm sạch môi trường sống của mèo, như thường xuyên vệ sinh nơi ở và khu vực vui chơi, cũng giúp giảm thiểu khả năng tiếp xúc với ve và bọ ký sinh. Hơn nữa, nên theo dõi sức khỏe của mèo thường xuyên để kịp thời phát hiện những điều bất thường.
Cùng với đó, nuôi mèo trong môi trường an toàn và được kiểm soát cũng là một yếu tố quan trọng để giảm thiểu nguy cơ nhiễm Cytauxzoon felis. Tránh cho mèo ra ngoài vào giờ cao điểm của ve, cũng như hạn chế tiếp xúc với các vật nuôi khác có thể bị nhiễm bệnh, là điều cần thiết. Ngoài ra, chủ nuôi có thể tham khảo ý kiến từ bác sĩ thú y về việc tiêm phòng cho mèo để bảo vệ sức khỏe tổng quát và khả năng miễn dịch của chúng.
Tóm lại, việc phòng ngừa Cytauxzoon felis cho mèo không chỉ bảo vệ tính mạng mà còn góp phần vào sự phát triển và hạnh phúc của chúng.
Lời khuyên từ bác sĩ thú y Dr. Vet
Đối với những người nuôi mèo, việc chăm sóc sức khỏe thú cưng là điều vô cùng quan trọng, đặc biệt là trong bối cảnh bệnh Cytauxzoon felis đang gia tăng. Bác sĩ thú y Dr. Vet nhấn mạnh rằng việc nhận diện sớm các triệu chứng của bệnh này và các vấn đề sức khỏe khác là điều cần thiết. Mèo có thể không thể tự nói lên cảm giác đau đớn của chúng, do đó, sự chú ý sát sao từ người nuôi là rất quan trọng.
Các triệu chứng phổ biến của Cytauxzoon felis bao gồm sốt, chán ăn, và suy nhược. Nếu bạn phát hiện thấy mèo của mình có bất kỳ dấu hiệu nào trong số này, việc đưa thú cưng đến gặp bác sĩ thú y nên được thực hiện ngay lập tức. Bác sĩ thú y Dr. Vet khuyên rằng việc kiểm tra sức khỏe định kỳ là một phần không thể thiếu trong chế độ chăm sóc mèo. Điều này giúp phát hiện sớm những vấn đề sức khỏe tiềm ẩn và đảm bảo điều trị kịp thời.
Ngoài ra, Dr. Vet cũng gợi ý rằng các chủ nuôi nên quan tâm đến môi trường sống của mèo. Hãy đảm bảo rằng mèo không tiếp xúc với côn trùng, đặc biệt là bọ chét và ve - những sinh vật có thể tiếp truyền Cytauxzoon felis. Sử dụng các biện pháp bảo vệ như thuốc chống ký sinh trùng và đảm bảo rằng thú cưng của bạn không ra ngoài một mình cũng sẽ giúp giảm nguy cơ lây nhiễm.
Mối quan hệ chặt chẽ giữa chủ nuôi và bác sĩ thú y là yếu tố quan trọng để duy trì sức khỏe cho mèo. Nên xây dựng thói quen thường xuyên gặp bác sĩ thú y để được tư vấn, cũng như nhận được các lời khuyên chính xác và kịp thời liên quan đến sức khỏe của thú cưng.

